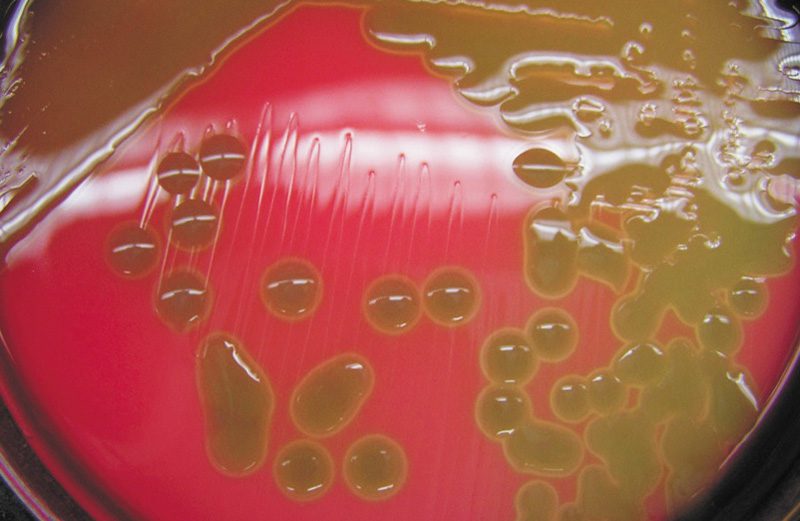

Стафилококк представляет собой бактерию, обитающую на кожной поверхности и слизистых слоях человеческого тела. При нормальном состоянии здоровья бактерия не дает о себе знать. Но достаточно иммунной системе дать сбой под воздействием различных факторов, и бактерии начинают активно размножаться, что негативно воздействует на состояние кожи и вызывает формирование стафилококка на лице и других частях тела.
Существует порядка 20 разновидностей стафилококковой инфекции, но к особо опасным относится:
Рассмотрим особенности размножения стафилококковой инфекции, ее проявление и лечебные принципы, позволяющие устранить негативную симптоматику.
Причины стафилококковых высыпаний на лице
Ухудшение состояния иммунной системы – основной фактор, в результате которого условно-патогенные микроорганизмы активизируются и превращаются в болезнетворные бактерии.
Однако имеются и другие причины, под воздействием которых начинаются такие изменения:
- На кожном покрове имеются поврежденные участки.
- Имеют место аутоиммунные заболевания.
- В организме протекают злокачественные процессы.
- Наличествуют патологии хронического течения.
- Имеются заболевания эндокринной железы.
- Из-за повышенного потоотделения изменяются бактерицидные свойства поверхности тела, и кожа превращается в плодотворную почву для размножения стафилококков.
- В окружающем мире наблюдаются резкие температурные перепады и имеются проблемы с экологией. Такие явления ухудшают защитные свойства кожи.
- Используемые косметические средства отличаются низким качеством и способствуют воспалительным процессам.
Следует учитывать и возрастную категорию, к которой относится человек.
Важно. Как показывает медицинская статистика, чаще всего стафилококк на лице развивается у детей. Особенно подвержены воздействию бактерий представители младшей возрастной группы в связи с не полностью сформировавшейся иммунной защитой кожного покрова.
Как проявляется стафилококк на кожной поверхности лица
Признаки стафилококковой инфекции зависят от разновидности воздействующей бактерии.
На коже лица могут возникать следующие кожные поражения:
- Фолликулит. Воспаления развиваются в верхних зонах фолликула. Кожный покров вокруг волоска, растущего из пораженного мешочка краснеет, в фолликуле формируется гнойник. После его вскрытия на коже лица появляется корочка либо эрозия. Зачастую фолликулит затрагивает обширные участки кожи.
- Фурункул. Причиной также становится воспаление волосяного мешочка, но при этом поражается и сальная железа рядом с ним, и соединительная ткань. Чаще всего именно золотистый стафилококк вызывает фурункулы на лице. Их отличает болезненность и некротические процессы, гиперемия кожи вокруг поражения. Иногда фурункулы формируются на затылочной области, на шее или спине.
- Карбункул. При его формировании поражается целая группа фолликулов, воспаление затрагивает кожную клетчатку на лице. На фото видно, что кожа при карбункуле приобретает синеватый отлив, появляются воронкообразные отверстия, откуда выделяются некротические массы, гной. Возникает общая слабость, повышается температура, возможна тошнота, приступы рвоты. Иногда наблюдается потеря сознания. Осложнения включают абсцессы тканей и развитие остеомиелита.
Гораздо реже на лице может развиться гидраденит. Его характеризуют воспалительные процессы, затрагивающие потовые железы.
Признаки развития золотистого стафилококка
Как было указанно выше, золотистый стафилококк является наиболее частым возбудителем инфекционных поражений.
Под его воздействием на лице появляются нарывы и воспалительные явления:
- Сикоз. Высыпания затрагивают подбородок, верхнюю губу. Цвет кожи приобретает синий оттенок, покров уплотняется. Терапия этой патологии занимает продолжительное время, при этом после терапии может проявиться вновь.
- Карбункулез. На лице появляется отечность, кожный покров уплотняется, приобретает темно-красный оттенок, на нем формируются гнойники, некроз, в выделениях наблюдаются кровянистые сгустки. После того, как ороговевший слой сходит, под ним часто обнаруживаются язвы, заживление которых формирует рубцы. Эта патология требует госпитализации, во время которой хирург занимается вскрытием карбункулов.
- Импетиго. Патология характеризуется появлением гнойников и пустул, наполненных гнойным содержимым. Место их локализации – область вокруг рта и около носа. Заболевание относится к заразным, его развитие сопровождается сильной болезненностью. Большое значение имеет возраст – чаще импетиго наблюдается у молодежи и у игнорирующих принципы гигиены.
Прочие признаки золотистого стафилококка
Помимо разнообразной сыпи на лице золотистый стафилококк проявляется себореей на кожном покрове головы, его повышенной жирностью. Учащаются простудные патологии, в течение всего времени держится субфебрильная температура. Развитие золотистого стафилококка может сопровождаться флегмоной, которая представляет собой сильную отечность кожи и ее покраснение. При формировании такого явления у взрослых пациентов наблюдается рост температуры и приступы тошноты.
Если заболевание не диагностировано и грамотное лечение отсутствует, стафилококк продолжает проникать в клетчатку, что способно вызвать отмирание тканей.
Еще одна опасность, возникающая, когда происходит поражение лица и области шеи – риск проникновения бактерии в мозг, учитывая близость кровеносных сосудов. Результатом может стать формирование менингита и абсцесса мозга.
Кроме того, стафилококки производят эндотоксин, провоцирующий пищевые отравления и синдром общей интоксикации, а в некоторых случаях приводящий к образованию токсического шока.
Принципы лечения стафилококковой инфекции
В случаях, когда у пострадавшего стафилококк локализуется на лице, лечение обещает быть долгим, поскольку эти бактерии отличаются повышенной сопротивляемостью к воздействию.
При этом терапия должна быть комплексной и включать:
- Применение противомикробных препаратов для внутривенных либо внутримышечных инъекций.
- Назначение витаминных курсов для улучшения состояния иммунной системы и предупреждения трансформации кожного заражения в подкожное. Параллельно с витаминами рекомендуется прием адаптогенов.
- Прописываются мази на базе антибиотиков, которым обрабатываются пораженные участки.
- Применяется аутогемотерапия, при которой кровь, отобранную из вены, вкалывают в мышцу.
- Дополнительным методом лечения может стать народная медицина.
Важно! Следует помнить о том, что бактерии отличаются повышенной стойкостью к антисептикам, сопротивляются кипячению как минимум 10 минут, не боятся замораживания, высушивания, переносят воздействия перекиси водорода и этилового спирта, исключая «зеленку».
Кроме того, золотистый стафилококк уверенно сопротивляется воздействию препаратов пенициллиновой группы, поскольку способен производить Лидазу и Пенициллиназу.
Какие препараты применяют чаще всего
Рассмотрим препараты, применяемые чаще всего для устранения явлений, вызываемых стафилококковой инфекцией:
- Из антисептиков лучшие рекомендации у Октенисепта, применение которого позволяет обеззаразить кожную поверхность при гнойных поражениях, стафилококковой ангине либо фарингите.
- Для местного лечения пораженного кожного покрова используют мазь Банеоцин, в которой содержится сразу два противомикробных препарата – Бацитрацин с Неомицином.
- Еще один противомикробный препарат в форме мази – Мупироцин, в него включены Бондерм, Супироцин и Бактробан.
- Применяют Имудон и ИРС19 – эти вещества являются лизатами бактерий и содержат измельченные микроорганизмы, вызывающие иммунный ответ. Результатом становится улучшение состояния иммунной системы. Препараты выпускают в форме таблеток, спрея.
- Для подкожного введения используют стафилококковый анатоксин, он помогает организму производить собственные антитела и безопасен для женщин, вынашивающих ребенка.
- Для уничтожения возбудителей могут использоваться бактериофаги, если стафилококк обладает фагочувствительностью.
Для повышения общего тонуса назначаются биогенные стимуляторы – Алоэ в виде мази, в сиропе и таблетках. Используют и стафилококковые вакцины, способствующие выработке иммунитета.
Народные рецепты против золотистого стафилококка
Эффективное лечение может включать применение народных рецептов, которые перед использованием рекомендуется обсудить с лечащим врачом.
Вот наиболее действенные рекомендации:
- Лист лопуха в сочетании с окопником. Равные части сухих измельченных растений запаривают в кипятке на протяжении 15 минут, фильтруют и пьют в утренние, дневные и вечерние часы до улучшения состояния.
- Свежий лист лопуха. Соком их листьев можно обрабатывать пораженную гнойниками кожу.
- Черная смородина. Ягоды кустарника хорошо укрепляют иммунную систему. За день следует съесть три стакана смородины, употребляя ягоды после трапез.
- Золотая колючка. Из растения делают отвар – две большие ложки высушенного сырья, высыпанные в мешочек из ткани, заваривают в литре закипевшей воды до момента, пока жидкость не приобретет золотистый цвет (если пациентом является ребенок) или ярко-желтый оттенок (для взрослых). Жидкость следует пить в течение дня, курс составляет десять суток. Также отвар подходит для протирания кожной поверхности.
Более простое средство – яблочный уксус. Для приготовления целебных ванн в теплой воде следует развести 50 грамм раствора. Длительность приема ванны составляет 15 минут, ее проводят три раза в течение дня. Для компресса в стакане воды разводят две больших ложки уксуса.
Поражения кожи лица — это воспаления из-за инфекций, аллергии, тепла и даже лекарств. Наружный покров устойчив к большинству воздействий, но по-прежнему уязвим в отношении захватчиков, таких как вирусы, бактерии, грибы. Стафилококк–это название группы бактерий, которая способна вызвать ряд заболеваний, включая инфекционные – стафилококк на лице. Строение большинства этих микроорганизмов напоминает виноградную гроздь фиолетового цвета (Staphylococcus с древнегреческого переводится как виноградное зерно).
Особенности инфицирования стафилококком
Сыпь – не что иное, как бактериальная инфекция на коже лица, вызванная стафилококком. Общие симптомы инфекции включают отек и покраснение в области глаз, щек и носа.
Причину нарушений при возникновении высыпаний на лице ищут внутри организма. Вирус способен поселиться как на поверхности кожных покровов, так и закрепиться изнутри в тканях человека.
Большинство людей только носители стафилококка, и инфекция у них не развивается. Однако если у человека проявились симптомы заболевания, это произошло из-за бактерий, которые годами спали в организме.
Стафилококк способен передаваться от человека к человеку. Он настолько вынослив, что способен жить на неодушевленных предметах (наволочках или полотенцах).
Инфекция неделями ожидает момента, чтобы перейти к следующему человеку. Бактерия устойчива к внешней среде и способна полгода хранится в засушенном или замороженном состоянии, не боится солнечных лучей, способна жить в воде и пищевых продуктах. Микроб с легкостью переносит желудочную кислоту и повышенный уровень соли.
Кроме этого известен еще ряд причин и факторов риска, благоприятных для развития заболевания:
- Низкий иммунитет.
- Занятия спортом (риск травмирования кожи). Бактерии могут легко распространяться через порезы, ссадины и контакт кожи с кожей, в раздевалке через общие бритвы, полотенца, униформу или оборудование.
- Дети (слабый иммунитет, не сформирована до конца защитная функция кожи).
- Аутоиммунные (инсулинозависимый сахарный диабет 1 и 2 типа) и онкологические заболевания (рак). Лекарства, химиотерапия и облучение радиацией способны ослабить иммунитет и усилить восприимчивость к инфекциям стафилококка.
- Почечная недостаточность, требующая диализа, ВИЧ, СПИД, респираторные заболевания.
- Очаги хронических инфекций, эндокринные заболевания, осложнения.
- Текущая или недавняя госпитализация. В больницах инфекция атакует уязвимых и ослабленных людей. Применение инвазивных устройств (диализные и дыхательные трубки, внутрисосудистые и мочевые катетеры) — риск попадания вируса из внешней среды внутрь организма.
- Приготовление пищи, не отвечающее санитарным требованиям (перенос инфекции с кожи на готовую пищу).
- Повышенный уровень потоотделения (нарушение бактерицидного барьера, развитие инфекции).
- Повреждение кожи экземой, ожоги, хирургические вмешательства, укусы насекомых.
- Косметика низкого качества (раздражения, воспалительный процесс).
- Экология.
Симптомы и признаки инфекции
Симптомы инфекции в области лица:
- бактерии стафилококка вызывают покраснение и отек;
- повышение температуры в области пораженного участка;
- поры расширены и выглядят больше, текстура кожи напоминает апельсиновую корку (целлюлит);
- области лица, пораженные инфекцией стафилококка, увеличены и болезненны для прикосновения;
- пациент испытывает зуд на опухшей коже;
- шейные лимфатические узлы чувствительны к прикосновениям;
- у некоторых пациентов с инфекцией стафилококка на лице язык чувствительный, опухший;
- на покрасневшей области часто выступает булла (пузырь), видны красные полосы, которые простираются от пораженного участка.
Из 30 штаммов стафилококка только три приводят к заболеванию. Наиболее опасными считают золотистый, эпидермальный, сапрофитный.
Каждый вид заболевания стафилококком выделяется наличием характерных признаков:
- фолликулит — воспаление в глубине кожи в области волосяных фолликулов, сопровождается покраснением гнойников и пустул с выделениями желто-зеленого цвета;
- фурункул — воспалительный процесс, который сопровождается появлением гноя в полостях кожи; иногда появляются множественные очаги, что говорит о наличии фурункулёза;
- карбункул-воронки с гноем внутри, кожа становится синюшного оттенка, начинается тошнота и рвота, возможна слабость и потеря сознания; промедление грозит абсцессом мягких тканей лица, развитием остеомиелита;
- импетиго – высыпания желтого (красного) цвета в виде фликтен (пузырей), просачиваются шишки, волдыри;
- гидраденит–заболевание сопровождается воспалительным процессом в области потовых желез на лице; на поверхности кожи возникают нагноения в виде прыщей, появляются припухлости и болезненные ощущения.
Методы диагностики
Врач-дерматолог способен определить заболевание по внешнему виду, на основании клинических признаков. Более серьезные инфекции стафилококка, такие как инфекция кровотока, пневмония и эндокардит, требуют культивирования образцов крови или инфицированных жидкостей и тканей организма. Анализы крови, которые показывают очень высокие концентрации лейкоцитов, могут указывать на инфекцию стафилококка, но диагноз подтверждают только после лабораторного анализа.
Микробиологическое исследование выделений – главный диагностический метод по выявлению инфицирования стафилококком, позволяют выявить род и вид возбудителя. Для этого у больных берется мазок. Материалом для исследования служит кровь, гной, выделения носа. Также используют кал, мочу или рвотные массы. Рентген помогает врачам найти внутренние абсцессы и оценить тяжесть инфекции. Биопсия иглой (отбор ткани, а затем ее исследование под микроскопом) может быть использована, чтобы выяснить, затронуты ли кости.
Характеристика высыпаний на лице
- пятно (меняется цвет кожи, степень пигментации, нечеткие края, отсутствует раздражение);
- бугорок (уплотнение без полости в глубоких слоях дермы, разрушение ткани, возможны рубцы, шрамы);
- волдырь (бесполостной элемент, результат воспалительного отёка верхнего слоя дермы, проходит в течение дня, не оставляет следов);
- узел (красные пятна, провоцируют воспаления);
- пустула (сыпь в результате воспаления, заполнена гноем, появляется в области лица и спины, образует рубцы и создает неравномерную пигментацию);
- папула (на поверхности кожи узелок розового цвета размером до 3 см).
Способы лечения, местная терапия
Стафилококк на лице всегда лечат комплексно. Первоначально подавляют патологические бактерии, затем лечат сопутствующие заболевания и укрепляют иммунитет. В сложных случаях применяют хирургические методы.
Антибиотики — основной способ в лечении стафилококковой инфекции на лице. Если заболевание в легкой форме, то терапия проводится с использованием пероральных антибиотиков, пациентов с тяжелой формой (стафилококковый синдром) госпитализируют и назначают внутривенные инъекции. Обычно используют антибиотики пенициллиновой группы. Для подавления бактерий применяют оксациллин, цефотаксим, сульфамидные препараты, нафциллин и ванкомицин. Выбор антибиотика делает врач в зависимости от тяжести заболевания и наличия у пациента аллергической реакции. После лечения существует вероятность повтора инфекции стафилококка на лице. По этой причине пациентам назначают более длительный курс антибиотиков для обеспечения полной ликвидации бактерий.
Стафилококк у пациента вызывает дискомфорт и боль, особенно если очаг инфекции расположен в области глаз (опухшая ткань ухудшает видимость). Консервативное лечение симптомов включает умывание теплой водой с применением антибактериальных средств, чтобы уменьшить воспаление. Помимо этого пациенту дополнительно назначают болеутоляющие Парацетамол и Ацетаминофен, лекарства для облегчения зуда.
Бороться с инфекцией стафилококка помогают бактериофаги – вирусы, способные определить и поразить клетки бактерий. Обеззаразить и восстановить кожу помогают мази с антибактериальными свойствами.
Хирургическое вмешательство проводят, если пациент страдает тяжелой формой заболевания. Иногда стафилококковая инфекция на лице провоцирует развитие абсцесса, когда происходит накопление гноя под кожей лица (фурункул, карбункул). Операция позволяет удалить гной из пораженных участков, снять отечность, вывести бактерии из абсцесса. При сильной инфекции на лице не исключен некроз тканей. У таких пациентов мертвые участки отсекаются, что дает возможность остальной коже лица восстановиться.
Общеукрепляющие средства
Противостоять микроорганизмам и бактериям помогает сильный иммунитет. Поддержать защиту организма на должном уровне поможет прием поливитаминных комплексов, растительных препаратов — адаптогенов (женьшень, элеутерококк), внутримышечное переливание очищенной собственной венозной крови (аутогемотерапия). Используют и сложные комбинации из синтетических иммуномодуляторов, когда вводят готовые иммунные препараты (стафилококковый иммуноглобулин).
Способы профилактики заболеваний
Меры профилактики и ряд предосторожностей помогут снизить риск развития стафилококковых инфекций:
- укрепить иммунитет (питание и регулярные физические нагрузки);
- личная гигиена (тщательно мыть руки), индивидуальные средства по уходу и личный гардероб (не использовать чужие зубные щетки, одежду, спортивное снаряжение);
- обрабатывать повреждения кожи, для перевязки использовать стерильные бинты и пластыри; повязка станет препятствием в распространении микроорганизмов за пределы раны, предотвратит попадание новых инфекций;
- одежду, детские игрушки, постельные белье мыть и стирать в горячей воде;
- термическая обработка продуктов и соблюдение санитарно-гигиенических норм в процессе приготовления пищи.
Множество микроорганизмов является составляющей микрофлоры нашего организма. Многие из них представляют определённую опасность для человека, но их минимальное содержание никак не вредит здоровью ребёнка.
Достаточно часто при профилактических осмотрах выявляют золотистый стафилококк, и многие приходят в ужас, узнав, что представляет собой этот микроорганизм.
Родители паникуют, узнав о том, что в детском саду у кого-то из детей выявили данный микроорганизм и боятся отводить малыша в дошкольное учреждение. Давайте разберёмся, что представляет собой стафилококковая инфекция, как её диагностировать и лечить.
Что такое?
Золотистый стафилококк – это особый вид бактерий, который входит в состав нормальной микрофлоры, выполняя положительные функции в организме. В основном проживает на слизистых оболочках носоглотки, а также в кишечнике. Тем не менее, это очень опасный микроорганизм, который вызывает различные инфекционные, воспалительные, гнойные заболевания, в последующем провоцирует серьезные осложнения. Каждый ребёнок и взрослый носит в себе этот опасный микроорганизм. С первого дня жизни дети подвержены патогенному росту этого микроба.
Стафилококк — это бактерия овальной формы, которая выделяет опасные для человека токсины. Выделяют 27 видов, 14 из которых проживают на слизистых оболочках и коже каждого человека, они устойчивы во внешней среде. Бактерия не поддается влиянию температур, воздействию антисептических средств, не образует спор.
Виды и степени болезни
Выделяют три основных вида стафилококка:
- staphylococcus aureus – золотистый стафилококк, самый агрессивный и всем известный вид, который выделяет токсичные для организма вещества и самое страшное – устойчив к антибактериальным препаратам;
- staphylococcus epidermidis – эпидермальный стафилококк, живёт на коже, но при этом не вызывает её поражений, скорее, при попадании в кровь вызывает заражение;
- staphylococcus saprophyticus – сапрофитный стафилококк, не представляет опасности для детей.
Выделяют две стадии стафилококковой инфекции:
- ранняя стадия характеризуется быстрым возникновением симптомов, которые возникают спустя несколько часов после заражения, проявляется слабостью, лихорадкой, рвотой, поносом;
- поздняя стадия проявляется через несколько дней. Первыми симптомами является поражение кожи в виде фурункулов.
После этого из ранок стафилококк попадает в кровь, и происходит заражение внутренних органов.
Как проявляется: симптомы и признаки
Важно отличать наличие стафилококка в организме, который, как правило, никак не проявляет себя при нормальном функционировании организма и иммунной системы, от стафилококковой инфекции, которая имеет определённую симптоматику и представляет собой опасность для ребёнка. Характерные симптомы, свидетельствующие о стафилококковой инфекции:
- слабость;
- вялость;
- высокая температура;
- точечная сыпь;
- одиночные язвочки;
- рвота;
- диарея;
- синдром «ошпаренной кожи»;
- гнойничковые высыпания;
- стафилококковая пневмония;
- абсцессы;
- флегмоны;
- гнойный менингит;
- пиодермия;
- эндокардит;
- остеомиелит;
- сепсис;
- токсический шок.
Эти проявления опасны для здоровья, поэтому при малейшем подозрении на стафилококковую инфекцию следует срочно обратиться к доктору.
Почему же ослабевает иммунитет и ребёнок подвержен развитию стафилококковой инфекции? Причиной бывают:
- недоношенность;
- приём матери во время беременности антибактериальных препаратов, противовоспалительных;
- стрессовые состояния во время беременности;
- стрессовые состояния ребёнка;
- авитаминоз матери во время беременности;
- авитаминоз ребёнка;
- неправильное питание;
- искусственное вскармливание;
- нарушение правил личной гигиены;
- дисбактериоз кишечника;
- частые инфекционные заболевания.
Как передается и чем опасен?
Стафилококковая инфекция опасна тем, что может привести к осложнениям, которые в дальнейшем могут не поддаваться лечению и развиваться, очень быстро ухудшая состояние ребёнка. Так, этот микроорганизм провоцирует возникновение и развитие многих тяжёлых заболеваний вплоть до перитонита, менингита и сепсиса. Эти тяжелейшие заболевания могут привести к летальному исходу.
Грудной ребёнок может заразиться от матери, к примеру, если у кормящей женщины есть трещины на сосках, и она их не обрабатывает антисептическими средствами. В данной ситуации может присоединиться стафилококк и, соответственно, передаться грудничку. Заражение может произойти также в больнице — это самое популярное место, где обитают стафилококки.
При рождении кроху может заразить медицинский персонал, если пользуется недостаточно продезинфицированными пелёнками, бутылочками, сосками.
Пути передачи инфекции разнообразны:
- контактно-бытовой – при контакте с заражёнными лицами;
- фекально-оральный – заражение через рот, самый частый метод, когда могут заразиться дети;
- перкутантный – через раны на коже;
- гематогенный – при оперативных вмешательствах, мелких хирургических манипуляциях.
В результате чего это поисходит?
- Снижение иммунитета. При этом ослабляются все защитные функции организма, и, помимо стафилококка, активируются различные возбудители, которые только способствуют снижению иммунитета и развитию разных простудных заболеваний.
- Нарушение правил гигиены. Ведь ребёнок всё познаёт через осязание предметов руками, а более маленькие дети берут всё в рот, чтобы познать окружающий мир. А что нужно для комфортных условий бактерий? Грязь, тепло, влага. Поэтому следует приучить ребёнка постоянно мыть руки с антисептическими средствами, особенно после прогулки и перед тем, как садиться за стол.
На данный момент существует множество антибактериальных средств для уборки. Помыв пол с таким средством, мама немного обезопасит ребёнка от попадания вредных микробов в организм. Также можно протирать поверхности, которых постоянно касается малыш антибактериальным средством.
- Третий момент — когда ваше дитя контактирует с больным со стафилококковой инфекцией. Работники детского сада проходят систематический профилактический медицинский осмотр, но порой и здесь можно встретить носителя этой инфекции. Он может заразить малышей детского сада, школьных учреждений, интернатов. Больше всего вероятность заразить детей — у тех, кто работает с едой на кухне, в таком случае поражение может стать массовым и составить невероятную проблему.
Молодым неопытным родителям важно знать, как уберечь ребёнка от столь опасной инфекции, откуда она берётся, как соблюдать гигиену ребёнку, как его этому обучить.
Как обнаружить?
Обычно родители замечают и жалуются доктору на то, что ребёнок слабый, вялый, больше спит, у него красные глаза, слезятся, возникают поносы, неизвестно откуда появляется рвота, повышается температура до высоких цифр.
Первое, что должен сделать доктор, это осмотреть малыша с ног до головы, все слизистые оболочки, а после направить родителей с ребёнком на бактериологические посевы, чтобы убедиться, что именно золотистый стафилококк является причиной ухудшения состояния.
Также можно выявить микроорганизмы в кале. Для этого родители собирают кал ребёнка и отдают в лабораторию на исследования. У детей 2-3 лет проще всего собрать самостоятельно кал, так как они используют свой собственный туалет – горшок. Анализ на дисбактериоз таже может выявить кишечную форму стафилококковой инфекции.
Большое количество стафилококка может быть в зеве, поэтому важно взять мазок оттуда. Затем следует направить ребёнка на ультразвуковое исследование внутренних органов.
Общий анализ крови будет также информативным: он будет свидетельствовать о наличии воспалительного процесса в организме. Будут повышены лейкоциты, нейтрофилы, эозинофилы, базофилы.
Как и чем можно вылечить?
Чтобы вылечить данную инфекцию у ребёнка, родителям не следует заниматься самолечением, вычитывать в различных источниках препараты, народные методы. Так как доктор подтверждает заболевание лабораторно-инструментальными исследованиями, он и подбирает каждому ребёнку личную дозировку. Также осуществляет тщательный подбор антибиотиков, зная об индивидуальных особенностях его организма.
Доктор использует схему лечения золотого стафилококка, которую следует выполнять родителям во благо своему ребёнку. Прежде всего, лечение должно быть подобрано так, чтобы препараты эффективно влияли на опасный микроорганизм.
Антибиотикотерапия. На этом этапе подбирается антибиотик, к которому будет наиболее восприимчива данная бактерия. Для начала используют препараты пенициллинового ряда. Доктор может назначить ряд препаратов, учитывая массу тела ребёнка, степень тяжести заболевания, форму, общее состояние ребёнка:
Частыми бывают ситуации, при которых невозможно назначить антибиотики пенициллинового ряда, к примеру, это могут быть аллергические реакции у ребёнка или какие-либо другие противопоказания. В этом случае назначаются антибактериальные препараты другой группы – цефалоспорины, к которым также чувствительны стафилококки:
При возникновении стафилококка на коже, помимо приёма антибиотиков внутрь, важно назначить ребёнку местную терапию. Поражение может локализоваться на лице, где важно более тщательное лечение, чтобы в последующем не осталось никаких рубцовых изменений.
На место образования фурункула назначаются антибактериальные мази, такие как, «Бактробан».
При лечении стафилококка желудочно-кишечного тракта прежде всего необходимо провести промывание желудка и кишечника. При этом используют бактериофаги и специальные смеси для ребёнка. Помимо этого важно, чтобы в кишечнике после промывания ничего не осталось: ни микробов, ни токсинов. Поэтому доктор может назначить абсорбирующие препараты, такие как:
- «Энтеросгель».
- Активированный уголь.
- Белый уголь.
- Многие другие адсорбенты.
Также для повышения защитных функций организма назначают иммуностимулирующие препараты:
Восстановительный этап в схеме лечения стафилококковой инфекции заключается в следующем:
- Для поддержания иммунной системы организма назначают витаминотерапию.
- Диета. Ребёнок должен полноценно питаться. Мясо, овощи, фрукты, каши, кисломолочные продукты — ни в коем случае нельзя ограничивать детей в потреблении одного из перечисленных продуктов питания.
- В период восстановления важно, чтобы малыш больше отдыхал и спал.
Возможно, при тяжёлом течении может быть необходима гемотрансфузия, то есть переливание крови.
Как защитить ребенка?
Как же всё-таки уберечь ребёнка от столь опасной инфекции, ведь стафилококк повсюду? Прежде всего соблюдайте личную гигиену ребёнка, питание должно соответствовать возрасту, быть рациональным и калорийным.
Если ваш малыш упал, сразу обработайте ранку антисептическим средством, либо всегда имейте под рукой маркер бриллиантового зелёного или йода. Таким образом, вы можете это сделать даже на улице, когда под рукой нет аптечки, а в сумочке есть отличное антибактериальное средство.
В осенне-зимне-весенний период проводите профилактику витаминами. Так как в это время иммунитет больше всего подвержен снижению за счёт низкой температуры и авитаминоза.
Старайтесь одевать ребёнка по погоде, чтобы он не переохлаждался и не перегревался, что также может спровоцировать снижение иммунной способности организма.
Мнение доктора Комаровского
По мнению доктора Комаровского, следует опасаться возникновения стафилококковой пневмонии, так как она обычно очень тяжело протекает у детей. Да и в целом, после того как ребёнок перенёс стафилококковую инфекцию, иммунитет находится в критическом состоянии, он не стабилен, его важно постоянно поддерживать, чтобы не возникло новой вспышки инфекционного заболевания.
Родители должны тщательно следить за иммунной системой крохи. Профилактически проводить витаминотерапию, иммуностимулирующую терапию, физиотерапевтические процедуры, которые способствуют повышению защитных функций организма. Постарайтесь не водить ребёнка, который подергался инфицированию стафилококком, в больницы, ведь там обитают самые опасные микроорганизмы, они устойчивы ко многим антибактериальным препаратам.
В следующем видео доктор Комаровский расскажет о том, как легче победить золотистый стафилококк.